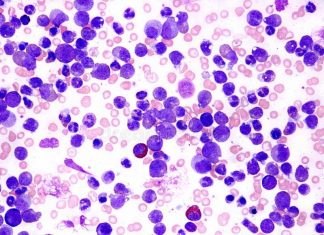
Study: New effective combination therapy for paediatric T-acute leukaemia Study: New effective combination therapy for paediatric T-acute leukaemia

New research finds simple approach is best for ablation procedures
Results from one of the largest global studies of atrial fibrillation (AFib) procedures show that the simple approach is usually best when it comes...
Exercise has cognitive benefits for people with Down Syndrome
Researchers at the University of Arizona (ASU) are conducting research to determine whether assisted and intense exercise can improve the emotional, cognitive and motor...
Study: New effective combination therapy for paediatric T-acute leukaemia
Acute lymphoblastic leukaemia (ALL) is the most common cancer affecting children. The T-ALL form of leukaemia that emerges from early T lineage cells has...
MRI can predict onset of multiple sclerosis
Magnetic resonance imaging (MRI) can measure atrophy in the brain, enabling it to be an accurate predictor of multiple sclerosis (MS), say a study...
Study: Three systems develop together for baby’s respiratory health
A new multidisciplinary study conducted by researchers at the University of Rochester Medical Center has found that the co-development of three systems, the gut...
Device can predict epilepsy seizures
The world's first study of its kind demonstrates that epileptic seizures in humans can be predicted by a device implanted in the brain, say...
University of Bath researchers unravel the mystery of genes that are...
Researchers are starting to understand the precise workings of a type of gene that, unlike other genes, does not code for proteins – the...
Study examines risk factors for attention-deficit/hyperactivity disorder
A new study assessed risk factors for attention-deficit/hyperactivity disorder (ADHD) and determined that both preterm birth and poor fetal growth were risk factors for...
Study: New solution for stem cell manufacturing
Researchers have developed a unique 3D printed system for harvesting stem cells from bioreactors, offering the potential for high quality, wide-scale production of stem...
Turmeric is useless unless combined with this spice
For thousands of years, turmeric has been used for medicinal purposes all over the world and over the past 25 years, over 3000 papers...